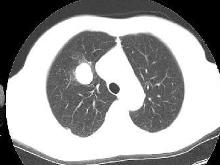
肺隔離症

概述
 肺隔離症
肺隔離症肺隔離症也稱為有異常動脈供血的肺囊腫症,是臨床上相對多見的先天性肺發育畸形。
病理病因
一、發病原因
在胚胎髮育期間,肺動脈發育不全使一部分肺組織血液供應受障礙,並由主動脈的分支代替肺動脈供應該區肺組織,由於來自主動脈的血液含氧量與來自肺動脈的血液完全不同,使該段肺組織的肺功能無法進行,因而發育不全,而無肺功能。
二、發病機制
肺隔離症的發生機制不清,常見有副肺芽學說、Prvce的牽引學說和Smith的血管發育不全學說。Prvce的牽引學說受到普遍承認,它認為在胚胎初期的原腸及肺芽周圍,有許多內臟毛細血管與背主動脈相連,當肺組織發生脫離時,這些相連的血管即逐漸衰退吸收。由於某種原因,發生血管殘存時,就成為主動脈的異常分支動脈,牽引一部分胚胎肺組織,形成肺隔離症。此部分肺組織與正常支氣管和肺動脈隔離開,由異常動脈供應血液。在胚胎早期肺組織與原腸發生脫離時受到牽引,副肺芽位於胸膜內,則形成葉內型肺隔離症,在脫離後受到牽引的異常的肺芽出現在胸膜已形成之後,則成為葉外型肺隔離症。但牽引學說並不能解釋所有的肺隔離症,有少數肺隔離症沒有異常動脈,或有異常動脈而無隔離肺。無論葉外型與葉內型,肺隔離症的主要動脈均來源於體循環的分支,主要是降主動脈,也可源於腹主動脈上部、腹腔動脈及其分支、升主或主動脈弓、無名動脈、鎖骨下動脈、內乳動脈、肋間動脈、膈動脈或腎動脈等。
多數經下肺韌帶進入隔離肺內,常為1支,也有2支或多支的情況,但較少見。動脈粗細不等,有的直徑可達1cm左右。這些異常動脈壁的結構與主動脈相似,含較多的彈性纖維組織,壓力較高,極易發生粥樣硬化。體循環血管如何發育到隔離肺內尚不清楚,正常情況下,肺動脈源於第6胚弓,且將它的分支延伸肺原基,最初供養肺胚芽的內臟血管叢分支逐步退化,僅保留下了支氣管動脈。根據公認的理論,背主動脈與肺芽周圍的內臟毛細血管間有豐富的側支交通,這些側支血管的某支吸收、退化不全,形成異常的體循環動脈供養隔離肺組織。同時因肺隔離症的胚胎組織處於異常部位,使肺循環血管不能發育。肺隔離症靜脈回流不盡一致:葉內型肺隔離症的血液回流入下肺靜脈,導致左-左分流,偶有葉內型回流到體循環靜脈。葉外型肺隔離症血液回流入半奇靜脈、奇靜脈、下腔靜脈、無名靜脈、肋間靜脈等,此時無分流問題。
臨床表現
肺隔離症多見於青少年,年齡在10~40歲,男性多於女性,葉內型多於葉外型,左側多於右側。由於肺隔離症分型不同,臨床表現不同,常見肺隔離症的臨床表現有:
1、葉外型肺隔離症 葉外型肺隔離症較葉內型少見,男女之比約為4∶1;左右側之比約2∶1。多位於下部胸腔的下葉與膈肌之間,鄰近正常肺組織,也可位於膈下、膈肌內或縱隔。多合併其他先天性畸形以先天性膈疝最為常見,約占30%。,其他有先天性支氣管囊腫、先天性食管支氣管瘺、肺不發育、先天性心臟病、異位胰腺及心包、結腸等臟器畸形等。但葉外型肺隔離症因有完整胸膜,猶如分離的肺葉,可視為副肺葉。因其不與支氣管相通,故質地柔韌,內含大小不等的多發囊腫。
病理:葉外型完全被胸膜包蓋,切面呈海綿狀、黑褐色組織,伴不規則排列的血管,通常在標本的一端更為顯著,鏡下呈正常肺組織無規律地異常排列,氣管數量很少,實質組織常發育不成熟。因其包有自己的胸膜,且不與支氣管相通,除非與消化道相通,感染的機會很少。因此,如沒有其他明顯的畸形,葉外型只是一軟組織包塊,可毫無症狀地存活到成人。
常見於新生兒,一般多無症狀,多在常規X線檢查時發現。一小部分葉外型肺隔離症可因合併畸形而在新生兒時期被發現。如與消化道相通也可見反覆呼吸道感染、乏力、呼吸困難等,晚期甚至可出現充血性心衰。60%合併同側膈膨升,30%合併左側膈疝,50%在屍檢、查體或檢查其他疾病時意外發現,90%在左肺。
2、葉內型肺隔離症 發病率低,但較葉外型多見,其2/3位於左下葉或右下葉後基底段,在椎旁溝內,與葉外型有以下不同:男女發病率相近,左右側比例1.5∶1~2∶1,多位於下葉的內、後基底段,很少合併其他先天性畸形,最常合併食管憩室、膈疝及其他骨、心畸形。病變組織無自身胸膜與正常肺組織隔離,故異常與正常肺組織間無明顯界限,共存於同一肺葉中。有1個或多個囊腔,實質部分更多,囊內充滿黏液。葉內型肺隔離症,特別是與支氣管相通的,幾乎所有病例在一定時期後均繼發感染,多數在10歲以前出現反覆肺部感染症狀,發熱、咳嗽、胸痛、咳膿痰甚至咳膿血痰,嚴重者還可出現全身中毒症狀,與肺膿腫症狀相似。感染時囊腔內為膿液,其常與支氣管或鄰近肺組織的氣管交通。查體局部叩診濁音,呼吸音減低,有時可聽到濕囉音,部分患者有杵狀指。體動脈多來自胸主動脈下部或腹主動脈上部,較為粗大,直徑0.5~2cm,異常動脈多在下肺韌帶內,經下肺韌帶到達病變部位,均經(下)肺靜脈回流,鏡下顯示類似擴張的支氣管,偶有管壁內軟骨板,有呼吸道上皮。異常肺組織伴有炎症、纖維化或膿腫。
左肺多見,60%在下葉後基底段,位於上葉者少見,15%無症狀,多在青壯年出現以下症狀:咳嗽、咳痰、咯血、反覆發作的肺部感染及心悸、氣短等。症狀多因病變與支氣管交通所致。經抗感染治療,症狀可暫時緩解,但病程也有遷延數月甚至數年之久的。
囊腫可單發或多發,大小不等,周圍肺組織常有肺炎,此時要待炎症消退後,才能證實陰影的囊性特徵,病變大小可隨時間有很大變化,主要依其內部的氣體、液體量。如果隔離肺有感染,其陰影形態可在很短時間內有很大變化。在呼氣時,可見隔離肺內有氣體滯留。
3、先天性支氣管肺前腸畸形 該詞常被用來代表一種畸形合併某些支氣管肺病變,但在此指的是與胃腸道交通的肺隔離症,最常見為肺隔離症的囊腔與食管下段或胃底交通,其病理特點符合葉內型或葉外型肺隔離症。Gede在1968年首次採用該詞描述,在該詞被採用前,此類肺隔離症被歸為葉外型。異常肺段最常見於食管(多在下段)交通,也可是胃。其右側多見,占70%~80%,男女發病率等,雖成人也可發病,但多在1歲前診斷,表現為:慢性咳嗽、反覆發作的肺炎或呼吸窘迫,常見伴隨其他畸形,如:葉外型肺隔離症及膈疝。
4、短彎刀綜合徵 Chassinant在1836年首先描述此綜合徵。含有以下3種畸形的疾病被稱為短彎刀綜合徵:①右肺發育不全;②右肺靜脈回流異常,肺靜脈匯入右心房和(或)下腔靜脈;③體動脈供血。因胸片有右心緣旁彎刀狀異常靜脈陰影而得名。其有明顯的家族傾向。
病理體動脈供血:最常表現為右肺上、中葉為肺動脈供血,而下葉有1根或更多體動脈血管供血,其可能起自胸主動脈下段,經下肺韌帶進入肺實質,或起自腹主動脈,穿過膈肌進入下肺韌帶。體動脈供血的肺組織可正常通氣或如隔離症樣無通氣,且顯示肺血管高壓。
靜脈回流異常:多僅有1根右肺靜脈,也可是2根,其引流全肺或僅限中、下葉靜脈血回流至下腔靜脈,故此綜合徵形成左向右分流,造成右心負荷過重,而右肺也不具備正常生理功能。異常肺靜脈與腔靜脈的匯合點可在膈上或膈下,兩者發生率相近。 右肺異常:常見右肺發育不全或發育不良,可伴支氣管畸形。
其他異常:此綜合徵可能合併的其他畸形有肺動脈缺失或發育不良、右位心、房間隔缺損、馬蹄肺等。
結合臨床表現、X線胸片特點,首先選用B超檢查,再根據情況進一步採用CT、MRI或血管造影檢查。
檢查鑑別
一、檢查
1、X線胸片 葉外型肺隔離症的胸部X線片常顯示均勻、三角形、尖端指向肺門的陰影,術前確診困難,常以胸內腫塊診斷不明而開胸探查。葉內型肺隔離症在胸部X線片上,見下葉內及後基底段緊貼膈面有一團密度均勻增深的陰影,大多為圓形、卵圓形,少數可呈三角形或多邊形,邊界一般較清晰,其長軸指向後方,提示與降主動脈有聯繫。如合併感染並與支氣管相通,則表現為單個或多個帶液平的圈形陰影,與肺囊腫影像相似。囊壁厚薄不等,周圍有炎變影像,陰影大小可隨病情病程演變而改變,感染時增大,炎症吸收後縮小,但絕不會完全消失。
2、體層攝影 下葉後段的病變在胸部平片上有時與脊柱或心臟陰影相重疊,體層攝影可清楚地顯示病變的形態、輪廓及內部結構。病變呈圓形、橢圓形或三角形,邊界清晰,可呈大小不等的囊性改變。有時在體層片上可見到異常血管影像與主動脈影相連,呈現出逗點狀或索條狀陰影,逗點的尾端代表異常動脈方向,具有診斷意義,但直徑0.5cm以下的異常血管不易發現。
3、支氣管造影病變內支氣管多數情況下不顯影,只有較大的支氣管可以顯影,加之造影后有可能引起感染,支氣管鏡檢查和支氣管造影多無意義。
肺隔離症
肺隔離症4、血管造影臨床高度懷疑肺隔離症而X線胸片及體層片不能確定時,主動脈造影或選擇性動脈造影,可以觀察到異常體動脈分支供應病變部位肺組織而得以明確診斷。經股動脈穿刺插管,於降主動脈起始部注造影劑造影可顯示,異常血管一般來自膈肌上下的降主動脈段,直徑為0.5~1cm。靜脈回流入肺靜脈或奇靜脈、下腔靜脈,但由於異常血管相對較細,造影劑量較少,多數情況下不能顯示靜脈回流情況。選擇性造影技術要求較高,經股動脈穿刺送入具有特殊角度的C形或直角形導管,於降主動脈膈肌上下尋找異常血管,導管尖端插入血管口內時注入造影劑,觀察血管直徑、走行,連續注入造影劑還可觀察到靜脈回流情況。但此項檢查是一種創傷性檢查,具有一定的危險性,而且需要一定的條件和設備。
5、CT檢查可以較清楚地顯示病變的形態,還可確認異常動脈的存在。典型表現為:正常肺支氣管動脈和靜脈束遠離或圍繞在隔離肺葉外周,偶見鈣化。如與支氣管樹交通造成感染,其表現為含氣囊腫,有或無液平,周圍可見炎性浸潤,也可呈囊腫樣表現,可有氣液平。但診斷陽性率並不高。
6、磁共振(MRI) 能檢測出胸內邊界清楚的團塊及其內部結構,在各個斷面尤其橫斷面上能清楚顯示,葉內型特點是在肺內異常的團塊(MRI上為增黑的陰影)和異常血管相連,葉外型是在肺外異常增白的團塊影,亦和異常血管相連。磁共振能看出異常肺組織及其與周圍臟器的關係,顯示異常動脈來源、走行及靜脈回流情況。其檢查結果與血管造影相似,又是無創傷的檢查方法,可以取代血管造影,但檢查費用較高。
7、B超可探測出邊界清楚、形態規整的圓形或橢圓形肺內團塊,內部可見大小不同的囊性區,如有感染時可見散在的小光點反射,團塊周圍可見0.5~0.8cm不等的1支或2支血管進入團塊。其影像特徵與其他肺內病變影像不同。B超是無創檢查方法,操作簡單,準確性高而且可以反覆動態觀察。但是B超不能區分葉內型或葉外型肺隔離症,亦不能檢測肺靜脈回流情況。
二、鑑別
葉內型肺隔離症與肺膿腫及支氣管擴張、Bochdalek疝及支氣管囊腫鑑別。有人認為吸入性肺膿腫幾乎從不發生在下葉,故下葉貼鄰膈面部位的囊腫應首先考慮為葉內型肺隔離症。
診斷
根據病史、臨床表現,結合影像學檢查(主要為增強CT)可做出診斷。
鑑別診斷
本病應與支氣管擴張症、肺炎、肺膿腫、肺腫瘤等鑑別,發現異常血管通向病變部分有助於臨床診斷。同時觀察是否合併其他畸形。
併發症
葉內型肺隔離症常並發肺炎。葉外型常合併其他畸形,如橫膈疝、室間隔缺損、肺靜脈異位引流、心包囊腫、漏斗胸、脊柱畸形、肺不發育等。
治療
1.葉內型肺隔離症可反覆繼發感染,故均應手術治療,多採用肺葉切除。手術應在控制感染後施行,並常規選用抗生素。因其常合併嚴重感染,患肺常粘連在胸壁上,分離這些粘連時必須注意異常動脈,異常動脈多存在於肺韌帶中,偶爾有來自腹主動脈的異常動脈,處理不當可造成術中及術後的致命大出血。
2.葉外型肺隔離症,如不與胃腸道交通、無症狀,可不予治療,但多因不能明確診斷而手術切除。葉外型肺隔離症可行隔離肺切除,一般行肺葉切除,手術當中要特別注意尋找和處理異常血管,尤其是在處理下肺韌帶時更要小心,一旦異常血管損傷退縮回腹腔或縱隔內,就會造成大出血,處理也較困難。
預後
手術切除預後好。

